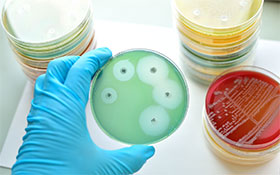

Erfahren Sie alles über Mikrobiologie, Bakterien und Hygienestandards in Lebensmittel-, Kosmetik-
und Pharma- Produkten. Unsere Steckbriefe bieten wissenschaftlich fundierte Informationen,
praxisnahe Erklärungen und aktuelle Erkenntnisse zur mikrobiologischen Qualitätssicherung.
Als unabhängiges Prüflabor unterstützen wir Hersteller und Fachkräfte mit transparentem Wissen
rund um Produktsicherheit, Mikrobiologische Analysen und Qualitätsmanagement.
Neueste Steckbriefe
Steckbrief zu Coliformen Bakterien im Trinkwasser
|
Allgemeines Eigenschaften
|
|
Herkunft / Auftreten
|
|
Bedeutung
Wichtig
|
|
Vermehrungsbedingungen
|
|
Abtötung durch Erhitzen
|
| Mögliche Ursachen für überhöhte Keimzahlen | Vorschläge für Maßnahmen |
| Bei Trinkwasser oder Prozesswasser am Wasserauslauf Wasserauslauf bzw. Armatur verunreinigt (auch Perlator berücksichtigen) |
|
| Bei Trinkwasser oder Prozesswasser (Ursache im Leitungsnetz) Leitungsnetz (Hausinstallation) verunreinigt, stehendes Wasser im System oder enthält einen Biofilm |
|
| Bei Trinkwasser oder Prozesswasser aus Leitungsnetz (Ursache sind eingebaute Teile/Anlagen) In der Hausinstallation befinden sind verunreinigte Filter und/oder Anlagen zur Wasseraufbereitung (z.B. Wasserenthärtungs- und Aufhärtungsanlagen, Filter-, Destillations-, UV-Systeme) |
|
|
Bei Trinkwasser aus Eigenwasserversorgungsanlagen, d.h. aus eigenen Brunnen und Quellen Verunreinigung durch Eingriff/Reparatur in der Quellfassung/Brunnenstube Verunreinigung nach Starkregen (Verunreinigung durch Oberflächenwasser) Verunreinigung durch Baumängel in der Quellfassung/Brunnenstube (Undichtigkeit, altersbedingte Abnutzungen) |
|
|
Bei Scherbeneis, Crushed Eis und Eiswürfeln in der Maschine inkl. Arbeitsgegenstände oder im Verbindungsschlauch (Zulaufwasser) oder im Leitungsnetz (Hausinstallation) |
|
|
An das Leitungsnetz (Hausinstallation) gebundene Wasserspender im Wasserspender |
|
Weitere Informationen und Literatur
www.bfr.bund.de unter: „Lebensmittelsicherheit“ → „Mikrobielle Risiken von Lebensmitteln“
www.bmel.de unter: „Themen“ → „Verbraucherschutz“ → „Lebensmittelsicherheit“
www.bvl.bund.de unter: „Arbeitsbereiche“ → „Lebensmittel“→ „Unerwünschte Stoffe und Organismen“
www.laves.niedersachsen.de unter: „Lebensmittel“ → „Lebensmittelhygiene“
www.lgl.bayern.de unter: „Lebensmittel“ → „Hygiene“
www.rki.de unter: „Infektionskrankheiten A-Z“/ „Mikrobiologische Diagnostik A-Z“
www.gesetze-im-internet.de unter: „Gesetze / Verordnungen“ → „TrinkwV
Energie/Wasser-praxis 11/2016 → Hygienische Sicherheit im Verteilungsnetz – Teil 2
Energie/Wasser-praxis 02/2016 → Mikrobiologische
Steckbrief zu Escherichia coli (E. coli) im Trinkwasser
|
Allgemeines Eigenschaften
|
|
Herkunft / Auftreten
|
|
Bedeutung
|
|
Vermehrungsbedingungen
|
|
Abtötung durch Erhitzen
|
| Mögliche Ursachen für überhöhte Keimzahlen | Vorschläge für Maßnahmen |
| Bei Trinkwasser oder Prozesswasser am Wasserauslauf Wasserauslauf bzw. Armatur verunreinigt (auch Perlator berücksichtigen) |
|
| Bei Trinkwasser oder Prozesswasser (Ursache im Leitungsnetz) Leitungsnetz (Hausinstallation) verunreinigt, stehendes Wasser im System oder enthält einen Biofilm |
|
| Bei Trinkwasser oder Prozesswasser aus Leitungsnetz (Ursache sind eingebaute Teile/Anlagen) In der Hausinstallation befinden sind verunreinigte Filter und/oder Anlagen zur Wasseraufbereitung (z.B. Wasserenthärtungs- und Aufhärtungsanlagen, Filter-, Destillations-, UV-Systeme) |
|
|
Bei Trinkwasser aus Eigenwasserversorgungsanlagen, d.h. aus eigenen Brunnen und Quellen Verunreinigung durch Eingriff/Reparatur in der Quellfassung/Brunnenstube Verunreinigung nach Starkregen (Verunreinigung durch Oberflächenwasser) Verunreinigung durch Baumängel in der Quellfassung/Brunnenstube (Undichtigkeit, altersbedingte Abnutzungen) |
|
|
Bei Scherbeneis, Crushed Eis und Eiswürfeln in der Maschine inkl. Arbeitsgegenstände im Verbindungsschlauch (Zulaufwasser) im Leitungsnetz (Hausinstallation) |
|
|
An das Leitungsnetz (Hausinstallation) gebundene Wasserspender im Wasserspender im Verbindungsschlauch (Zulaufwasser) im Leitungsnetz (Hausinstallation) |
|
Weitere Informationen und Literatur
www.bfr.bund.de unter: „Lebensmittelsicherheit“ → „Mikrobielle Risiken von Lebensmitteln“
www.bmel.de unter: „Themen“ → „Verbraucherschutz“ → „Lebensmittelsicherheit“
www.bvl.bund.de unter: „Arbeitsbereiche“ → „Lebensmittel“→ „Unerwünschte Stoffe und Organismen“
www.laves.niedersachsen.de unter: „Lebensmittel“ → „Lebensmittelhygiene“
www.lgl.bayern.de unter: „Lebensmittel“ → „Hygiene“
www.rki.de unter: „Infektionskrankheiten A-Z“/ „Mikrobiologische Diagnostik A-Z“
www.gesetze-im-internet.de unter: „Gesetze / Verordnungen“ → „TrinkwV
Energie/Wasser-praxis 11/2016 → Hygienische Sicherheit im Verteilungsnetz – Teil 2
Energie/Wasser-praxis 02/2016 → Mikrobiologische Grundlage einzelner trinkwasserrelevanter Erreger und gesundheitliche Aspekte
Steckbrief zur Koloniezahl bei +22 °C und +36 °C im Trinkwasser
|
Allgemeines
|
|
Herkunft / Auftreten
|
|
Bedeutung allgemein
Bedeutung Koloniezahl bei +22 °C
Bedeutung Koloniezahl bei +36 °C
|
|
Vermehrungsbedingungen
|
|
Abtötung durch Erhitzen
|
| Mögliche Ursachen für überhöhte Keimzahlen | Vorschläge für Maßnahmen |
| Bei Trinkwasser oder Prozesswasser am Wasserauslauf Wasserauslauf bzw. Armatur verunreinigt (auch Perlator berücksichtigen) |
|
|
Bei Trinkwasser oder Prozesswasser (Ursache im Leitungsnetz) |
|
| Bei Trinkwasser oder Prozesswasser aus Leitungsnetz (Ursache sind eingebaute Teile/Anlagen) In der Hausinstallation befinden sind verunreinigte Filter und/oder Anlagen zur Wasseraufbereitung (z.B. Wasserenthärtungs- und Aufhärtungsanlagen, Filter-, Destillations-, UV-Systeme) |
|
|
Bei Trinkwasser aus Eigenwasserversorgungsanlagen, d.h. aus eigenen Brunnen und Quellen Verunreinigung durch Eingriff/Reparatur in der Quellfassung/Brunnenstube Verunreinigung nach Starkregen (Verunreinigung durch Oberflächenwasser) Verunreinigung durch Baumängel in der Quellfassung/Brunnenstube (Undichtigkeit, altersbedingte Abnutzungen) |
|
|
Bei Scherbeneis, Crushed Eis und Eiswürfeln in der Maschine inkl. Arbeitsgegenstände im Verbindungsschlauch (Zulaufwasser) im Leitungsnetz (Hausinstallation) |
|
|
An das Leitungsnetz (Hausinstallation) gebundene Wasserspender im Wasserspender im Verbindungsschlauch (Zulaufwasser) im Leitungsnetz (Hausinstallation) |
|
Weitere Informationen und Literatur
www.gesetze-im-internet.de unter: „Gesetze / Verordnungen“ → „TrinkV“
Energie/Wasser-praxis 11/2016 → Hygienische Sicherheit im Verteilungsnetz – Teil 2
Energie/Wasser-praxis 02/2015 → Mikrobiologische Grundlage einzelner trinkwasserrelevanter Erreger und gesundheitliche Aspekte
Steckbrief zu Pseudomonas aeruginosa im Trinkwasser
|
Allgemeines Eigenschaften
|
|
Herkunft / Auftreten
|
|
Bedeutung
|
|
Vermehrungsbedingungen
|
|
Abtötung durch Erhitzen
|
| Mögliche Ursachen für überhöhte Keimzahlen | Vorschläge für Maßnahmen |
| Bei Trinkwasser oder Prozesswasser am Wasserauslauf Wasserauslauf bzw. Armatur verunreinigt (auch Perlator berücksichtigen) |
|
| Bei Trinkwasser oder Prozesswasser (Ursache im Leitungsnetz) Leitungsnetz (Hausinstallation) verunreinigt, stehendes Wasser im System oder enthält einen Biofilm |
|
| Bei Trinkwasser oder Prozesswasser aus Leitungsnetz (Ursache sind eingebaute Teile/Anlagen) In der Hausinstallation befinden sind verunreinigte Filter und/oder Anlagen zur Wasseraufbereitung (z.B. Wasserenthärtungs- und Aufhärtungsanlagen, Filter-, Destillations-, UV-Systeme |
|
|
Bei Trinkwasser aus Eigenwasserversorgungsanlagen, d.h. aus eigenen Brunnen und Quellen Verunreinigung durch Eingriff/Reparatur in der Quellfassung/Brunnenstube Verunreinigung nach Starkregen (Verunreinigung durch Oberflächenwasser) Verunreinigung durch Baumängel in der Quellfassung/Brunnenstube (Undichtigkeit, altersbedingte Abnutzungen) |
|
|
Bei Scherbeneis, Crushed Eis und Eiswürfeln in der Maschine inkl. Arbeitsgegenstände im Verbindungsschlauch (Zulaufwasser) im Leitungsnetz (Hausinstallation) |
|
|
An das Leitungsnetz (Hausinstallation) gebundene Wasserspender im Wasserspender im Verbindungsschlauch (Zulaufwasser) im Leitungsnetz (Hausinstallation) |
|
Weitere Informationen und Literatur
www.bfr.bund.de unter: „Lebensmittelsicherheit“ → „Mikrobielle Risiken von Lebensmitteln“
www.bmel.de unter: „Themen“ → „Verbraucherschutz“ → „Lebensmittelsicherheit“
www.bvl.bund.de unter: „Arbeitsbereiche“ → „Lebensmittel“→ „Unerwünschte Stoffe und Organismen“
www.laves.niedersachsen.de unter: „Lebensmittel“ → „Lebensmittelhygiene“
www.lgl.bayern.de unter: „Lebensmittel“ → „Hygiene“
www.rki.de unter: „Infektionskrankheiten A-Z“/ „Mikrobiologische Diagnostik A-Z“
www.gesetze-im-internet.de unter: „Gesetze / Verirdungen“ → „TrinkwV
Energie/Wasser-praxis 11/2016 → Hygienische Sicherheit im Verteilungsnetz – Teil 2
Energie/Wasser-praxis 02/2016 → Mikrobiologische Grundlage einzelner trinkwasserrelevanter Erreger und gesundheitliche Aspekte
Steckbrief zu Clostridium perfringens im Trinkwasser
|
Allgemeines Eigenschaften
|
|
Herkunft / Auftreten
|
|
Bedeutung
|
|
Krankheitsbild
|
|
Vermehrungsbedingungen und Toxinproduktion
|
|
Abtötung durch Erhitzen
|
| Mögliche Ursachen für überhöhte Keimzahlen | Vorschläge für Maßnahmen |
| Bei Trinkwasser oder Prozesswasser am Wasserauslauf Wasserauslauf bzw. Armatur verunreinigt (auch Perlator berücksichtigen) |
|
| Bei Trinkwasser oder Prozesswasser (Ursache im Leitungsnetz) Leitungsnetz (Hausinstallation) verunreinigt, stehendes Wasser im System oder enthält einen Biofilm |
|
| Bei Trinkwasser oder Prozesswasser aus Leitungsnetz (Ursache sind eingebaute Teile/Anlagen) In der Hausinstallation befinden sind verunreinigte Filter und/oder Anlagen zur Wasseraufbereitung (z.B. Wasserenthärtungs- und Aufhärtungsanlagen, Filter-, Destillations-, UV-Systeme) |
|
|
Bei Trinkwasser aus Eigenwasserversorgungsanlagen, d.h. aus eigenen Brunnen und Quellen Verunreinigung durch Eingriff/Reparatur in der Quellfassung/Brunnenstube Verunreinigung nach Starkregen (Verunreinigung durch Oberflächenwasser) Verunreinigung durch Baumängel in der Quellfassung/Brunnenstube (Undichtigkeit, altersbedingte Abnutzungen) |
|
|
Bei Scherbeneis, Crushed Eis und Eiswürfeln in der Maschine inkl. Arbeitsgegenstände im Verbindungsschlauch (Zulaufwasser) im Leitungsnetz (Hausinstallation) |
|
|
An das Leitungsnetz (Hausinstallation) gebundene Wasserspender im Wasserspender im Verbindungsschlauch (Zulaufwasser) im Leitungsnetz (Hausinstallation) |
|
Weitere Informationen und Literatur
www.bfr.bund.de unter: „Lebensmittelsicherheit“ → „Mikrobielle Risiken von Lebensmitteln“
www.bmel.de unter: „Themen“ → „Verbraucherschutz“ → „Lebensmittelsicherheit“
www.bvl.bund.de unter: „Arbeitsbereiche“ → „Lebensmittel“→ „Unerwünschte Stoffe und Organismen“
www.laves.niedersachsen.de unter: „Lebensmittel“ → „Lebensmittelhygiene“
www.lgl.bayern.de unter: „Lebensmittel“ → „Hygiene“
www.rki.de unter: „Infektionskrankheiten A-Z“/ „Mikrobiologische Diagnostik A-Z“
www.gesetze-im-internet.de unter: „Gesetze / Verordnungen“ → „TrinkwV
Energie/Wasser-praxis 11/2016 → Hygienische Sicherheit im Verteilungsnetz – Teil 2
Energie/Wasser-praxis 02/2016 → Mikrobiologische Grundlage einzelner trinkwasserrelevanter Erreger und gesundheitliche Aspekte
Steckbrief zu Legionellen im Trinkwasser
|
Allgemeines
Eigenschaften
|
|
Herkunft/Auftreten
|
|
Bedeutung
|
|
Gesetzliche Vorschriften für Trinkwasser
|
|
Krankheitsbild
|
|
Beispiele betroffener Wassersysteme
|
|
Vermehrungsbedingungen
|
|
Abtötung durch Erhitzen und andere technische Maßnahmen
|
| Mögliche Ursachen für überhöhte Keimzahlen | Vorschläge für Maßnahmen |
|
Bei Legionellen in Trinkwasser Stagnation des Wassers bei Nichtnutzung, d.h. Austausch nach 7 Tagen, besser nach als 3 Tagen (ansonsten Gefahr der Biofilmbildung) Regelmäßiges Durchspülen der Leitungen (Protokolle, Dokumentation prüfen) Unzureichende Nutzung der Leitung und/oder „Totstränge“ mit Stagnation oder anderen technisch – baulichen Mängeln am Leitungsnetz Ablagerungen und Biofilme Verschmutzung/Verschleiß von Geräten/Anlagen und Perlatoren/Schläuchen, die an das Trinkwassernetz angeschlossen sind |
|
Weitere Informationen und Literatur
www.gesetze-im-internet.de unter: „Gesetze / Verordnungen“ → „TrinkV“
Energie/Wasser-praxis 11/2016 → Hygienische Sicherheit im Verteilungsnetz – Teil 2
Energie/Wasser-praxis 02/2015 → Mikrobiologische Grundlage einzelner trinkwasserrelevanter Erreger und gesundheitliche Aspekte
UBA_Trinkwasser-Ratgeber_2020-04-07
twin09-2014-01
DVGW_Stilllegung von Trinkwasser-Installationen_2020-03-24
Steckbrief zu Intestinale Enterokokken im Trinkwasser
|
Allgemeines Eigenschaften
|
|
Herkunft / Auftreten
|
|
Bedeutung
Wichtig
|
|
Vermehrungsbedingungen
|
|
Abtötung durch Erhitzen
|
| Mögliche Ursachen für überhöhte Keimzahlen | Vorschläge für Maßnahmen |
| Bei Trinkwasser oder Prozesswasser am Wasserauslauf Wasserauslauf bzw. Armatur verunreinigt (auch Perlator berücksichtigen) |
|
| Bei Trinkwasser oder Prozesswasser (Ursache im Leitungsnetz) Leitungsnetz (Hausinstallation) verunreinigt, stehendes Wasser im System oder enthält einen Biofilm |
|
|
Bei Trinkwasser oder Prozesswasser aus Leitungsnetz (Ursache sind eingebaute Teile/Anlagen) |
|
|
Bei Trinkwasser aus Eigenwasserversorgungsanlagen, d.h. aus eigenen Brunnen und Quellen Verunreinigung durch Eingriff/Reparatur in der Quellfassung/Brunnenstube Verunreinigung nach Starkregen (Verunreinigung durch Oberflächenwasser) Verunreinigung durch Baumängel in der Quellfassung/Brunnenstube (Undichtigkeit, altersbedingte Abnutzungen) |
|
|
Bei Scherbeneis, Crushed Eis und Eiswürfeln in der Maschine inkl. Arbeitsgegenstände im Verbindungsschlauch (Zulaufwasser) im Leitungsnetz (Hausinstallation) |
|
|
An das Leitungsnetz (Hausinstallation) gebundene Wasserspender im Wasserspender im Verbindungsschlauch (Zulaufwasser) im Leitungsnetz (Hausinstallation) |
|
Weitere Informationen und Literatur
www.bfr.bund.de unter: „Lebensmittelsicherheit“ → „Mikrobielle Risiken von Lebensmitteln“
www.bmel.de unter: „Themen“ → „Verbraucherschutz“ → „Lebensmittelsicherheit“
www.bvl.bund.de unter: „Arbeitsbereiche“ → „Lebensmittel“→ „Unerwünschte Stoffe und Organismen“
www.laves.niedersachsen.de unter: „Lebensmittel“ → „Lebensmittelhygiene“
www.lgl.bayern.de unter: „Lebensmittel“ → „Hygiene“
www.rki.de unter: „Infektionskrankheiten A-Z“/ „Mikrobiologische Diagnostik A-Z“
www.gesetze-im-internet.de unter: „Gesetze / Verordnungen“ → „TrinkwV
Energie/Wasser-praxis 11/2016 → Hygienische Sicherheit im Verteilungsnetz – Teil 2
Energie/Wasser-praxis 02/2016 → Mikrobiologische Grundlage einzelner trinkwasserrelevanter Erreger und gesundheitliche Aspekte
Steckbrief zu präsumtiven Bacillus cereus in Lebensmitteln
|
Allgemeines Eigenschaften
|
|
Herkunft / Auftreten
|
|
Bedeutung
|
|
Krankheitsbild
|
|
Beispiele betroffener Lebensmittel
→ Lebensmittel pflanzlicher Herkunft, insbesondere stärkehaltige Produkte, sind deutlich häufiger Verursacher von Magen-Darm-Erkrankungen als Lebensmittel tierischer Herkunft |
|
Vermehrungsbedingungen und Toxinproduktion
|
|
Abtötung durch Erhitzen
|
| Mögliche Ursachen für überhöhte Keimzahlen | Vorschläge für Maßnahmen |
| Fehler beim Erhitzen, Warmhalten oder Abkühlen: Die Folge ist eine unzureichende Abtötung von Mikroorganismen aufgrund unzureichender Erhitzung oder eine starke Keimvermehrung aufgrund zu niedriger Warmhaltetemperaturen in Verbindung mit zu langen Abkühlphasen |
|
| Fehler bei der Kühlung oder zu lange Haltbarkeitsdauer: Die Folge ist eine zu starke Vermehrung von Mikroorganismen aufgrund von Unterbrechungen der Kühlkette, zu hohe Lagertemperaturen oder einer Überlagerung (zu lange Haltbarkeit) der Lebensmittel |
|
| Einsatz mikrobiell belasteter Rohstoffe oder Zutaten: Sind im Prozess keine sicheren Abtötungsschritte vorhanden, können die daraus hergestellten Lebensmittel potenziell mikrobiell belastet sein (z. B. Kräuter, Gewürze, …) |
|
| Fehler beim landwirtschaftlichen Anbau, Ernte oder nachgelagerten Prozessen: Kontamination von pflanzlichen Lebensmitteln beim Anbau durch Ausscheidungen von Tieren, verunreinigtes Wasser bzw. Düngemittel oder Personal |
|
| Fehler bei der Reinigung und Desinfektion: Die Folge sind Kontaminationen von Lebensmitteln durch z.B. mikrobiell verunreinigte Arbeitsgeräte, -gegenständen, -oberflächen oder Maschinen |
|
Weitere Informationen und Literatur
www.bfr.bund.de unter: „Lebensmittelsicherheit“ → „Mikrobielle Risiken von Lebensmitteln“
www.bmel.de unter: „Themen“ → „Verbraucherschutz“ → „Lebensmittelsicherheit“
www.bvl.bund.de unter: „Arbeitsbereiche“ → „Lebensmittel“→ „Unerwünschte Stoffe und Organismen“
www.laves.niedersachsen.de unter: „Lebensmittel“ → „Lebensmittelhygiene“
www.lgl.bayern.de unter: „Lebensmittel“ → „Hygiene“
www.rki.de unter: „Infektionskrankheiten A-Z“/ „Mikrobiologische Diagnostik A-Z“
Steckbrief zu Staphylococcus aureus in Kosmetika
|
Allgemeines Eigenschaften
|
|
Herkunft / Auftreten
|
|
Bedeutung
|
|
Wichtiger Hinweis
|
|
Vermehrungsbedingungen
|
|
Abtötung durch Erhitzen
|
| Mögliche Ursachen für überhöhte Keimzahlen | Vorschläge für Maßnahmen |
| Reinigung und Desinfektion: Mikrobiell verunreinigte Arbeitsgeräte, -gegenstände oder -oberflächen, mangelnde Produktionshygiene |
|
| Rohstoffe und Zutaten: Einsatz mikrobiell belasteter oder falscher Rohstoffe oder Zutaten |
|
| Trennung „rein und unrein“: Unzureichende Trennung von reinen und unreinen Arbeitsbereichen |
|
| Personalhygiene: Zum Beispiel Fehler bei der Händehygiene und Sauberkeit der Arbeitskleidung |
|
| Umgebungs- und Lagerbedingungen: Zum Beispiel zu hohe Luftkeimzahlen oder hohe Luftfeuchtigkeit und Bildung von Kondenswasser |
|
| Produktionsfehler: Fehlerhafte Prozesse, z.B. durch unzureichende Mischzeiten oder Kreuzkontamination |
|
| Erhitzen: Fehler bei der Herstellung (z. B. unzureichende Erhitzung) |
|
| Konservierungssystem: Unzureichendes Konservierungssystem |
|
Weitere Informationen und Literatur
https://www.bfr.bund.de/produktsicherheit/gesundheitliche-bewertung-von-kosmetischen-mitteln/
Fachgruppe Mikrobiologie und Betriebshygiene der DGK e.V.
Allgemeine Informationen und Publikationen
https://dgk-ev.de/mikrobiologie-und-betriebshygiene
Fachbuch „DGK-Betriebshygiene in der Kosmetik“
https://www.sofw.com/de/shop/buecher/product/386-dgk-betriebshygiene-in-der-kosmetik-2-ueberarbeitete-ausgabe-2019
Fachbuch „DGK-Konservierung kosmetischer Mittel“
https://www.sofw.com/de/shop/buecher/product/66-dgk-konservierung-kosmetischer-mittel
Fachbereich Kosmetika in der Arbeitsgruppe Lebensmittelchemie, Kosmetik, Gebrauchsgegenstände
der GÖCH
Allgemeine Informationen und Leitfäden
https://www.goech.at/arbeitsgruppen/lebensmittel%2C-kosmetik-%26-gebrauchsgegenst%C3%A4nde
ISO-Norm 17516 zu mikrobiologischen Grenzwerten
https://www.beuth.de/de/norm/din-en-iso-17516/203537217
ISO-Norm 29621 zur Einstufung mikrobiologisch risikoarmer Produkte
https://www.beuth.de/de/norm/din-en-iso-29621/263888044
Steckbrief zu Schimmelpilzen in Kosmetika
|
Allgemeines Schimmelpilze sind in unserer Umwelt weit verbreitet und können deshalb auch in kosmetischen Mitteln vorkommen. In Kosmetika gelten sie als typische Verderbniserreger, die ein hygienisches oder toxikologisches Risiko darstellen können. Die ISO 17516 legt auch Grenzwerte fest für die Gesamtanzahl aerober Mikroorganismen. Dies ist die Summe der Anzahl an Bakterien, Hefen und Schimmelpilzen. Für Kosmetika im Allgemeinen liegen diese Grenzwerte bei 1000 KBE. Für Kosmetika für Kinder unter 3 Jahren sowie bei Anwendungen in sensiblen Bereichen wie Augen, Mund oder im Intimbereich liegt der Grenzwert bei 100 KBE/g Eigenschaften
|
|
Herkunft / Auftreten
|
|
Bedeutung
|
|
Vermehrungsbedingungen
|
|
Abtötung durch Erhitzen
|
| Mögliche Ursachen für überhöhte Keimzahlen | Vorschläge für Maßnahmen |
|
Fehler bei der Reinigung und Desinfektion sowie unzureichende Hygiene bei der Belüftung: Hinweis zur Lufthygiene: Eine unzureichende Belüftung, unhygienische Belüftungsanlagen, hohe Luftfeuchtigkeit und hohe Feuchte an Decken, Wänden und Fenstern können zu überhöhten Keimzahlen an Schimmelpilzen in der Luft führen |
|
| Einsatz mikrobiell belasteter Rohstoffe: Wenn zur Produktion mikrobiell belastete Rohstoffe eingesetzt werden und sich in den weiteren Produktionsschritten keine sicheren Abtötungsschritte befinden, ist das Produkt dadurch ebenfalls potenziell mikrobiell belastet |
|
| Fehlerhaftes Konservierungssystem: Ein unzureichendes Konservierungssystem hat eine unerwünschte Vermehrung oder unzureichende Abtötung von Mikroorganismen zur Folge |
|
| Produktionsfehler: Fehlerhafte Prozesse, z.B. durch unzureichende Mischzeiten, Rezepturabweichungen, unzureichende Erhitzung oder Kreuzkontamination |
|
| Fehlerhafte Umgebungs- und Lagerbedingungen: Hohe Luftkeimzahlen, hohe Luftfeuchtigkeit oder die Bildung von Kondenswasser können zu mikrobiologischen Kontaminationen führen |
|
Weitere Informationen und Literatur
https://www.bfr.bund.de/produktsicherheit/gesundheitliche-bewertung-von-kosmetischen-mitteln/
Fachgruppe Mikrobiologie und Betriebshygiene der DGK e.V.
Allgemeine Informationen und Publikationen
https://dgk-ev.de/mikrobiologie-und-betriebshygiene
Fachbuch „DGK-Betriebshygiene in der Kosmetik“
https://www.sofw.com/de/shop/buecher/product/386-dgk-betriebshygiene-in-der-kosmetik-2-ueberarbeitete-ausgabe-2019
Fachbuch „DGK-Konservierung kosmetischer Mittel“
https://www.sofw.com/de/shop/buecher/product/66-dgk-konservierung-kosmetischer-mittel
Fachbereich Kosmetika in der Arbeitsgruppe Lebensmittelchemie, Kosmetik, Gebrauchsgegenstände
der GÖCH
Allgemeine Informationen und Leitfäden
https://www.goech.at/arbeitsgruppen/lebensmittel%2C-kosmetik-%26-gebrauchsgegenst%C3%A4nde
ISO-Norm 17516 zu mikrobiologischen Grenzwerten
https://www.beuth.de/de/norm/din-en-iso-17516/203537217
ISO-Norm 29621 zur Einstufung mikrobiologisch risikoarmer Produkte
https://www.beuth.de/de/norm/din-en-iso-29621/263888044